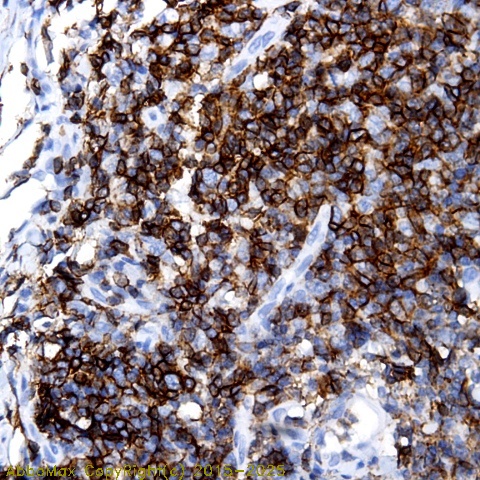

Lambda Light chain
Immunoglobulin lambda light chain
 Download Product PDF
Download Product PDF
 MSDS Download Product PDF
MSDS Download Product PDF
Antigen Preparation
Immunoglobulin Light chain
Background
"Lambda light chains are polypeptide chains located in the cell membrane and cytoplasmic regions of normal B cells and plasma cells. The combination of lambda light chains and heavy chains forms immunoglobulin molecules. There are two classes of light chains found in immunoglobulins, kappa light chains and lambda light chains. Light chain production by lymphoid cells is genetically restricted such that the immunoglobulin molecules produced by an individual cell will only contain a single light chain class. This clonal restriction may be used to indicate the polyclonal or monoclonal nature of B cell and plasma cell populations. The ratio of Kappa to Lambda is about 2:1. The level of kappa or lambda can be greatly elevated in multiple myeloma or other B cell malignancies."
PURIFICATION
The Rabbit IgG is purified by Epitope Affinity Purification
|
SPECIFICITY
This antbody recognizes human Lambda Light chain. The other species not tested.
|
FORMULATION
This affinity purified antibody is supplied in sterile Phosphatebuffered saline (pH7.2) containing antibody stabilizer
|
STORAGE
The antibodies are stable for 24 months from date of receipt when stored at –20oC to –70oC. The antibodies can be stored at 2oC-8oC for three month without detectable loss of activity. Avoid repeated freezing-thawing cycles.
|
Applications/Suggested Working Dilutions
|
|
|
Immunoprecipitation
2-5 µg/ml
|
|
Flow cytometry
Not tested
|